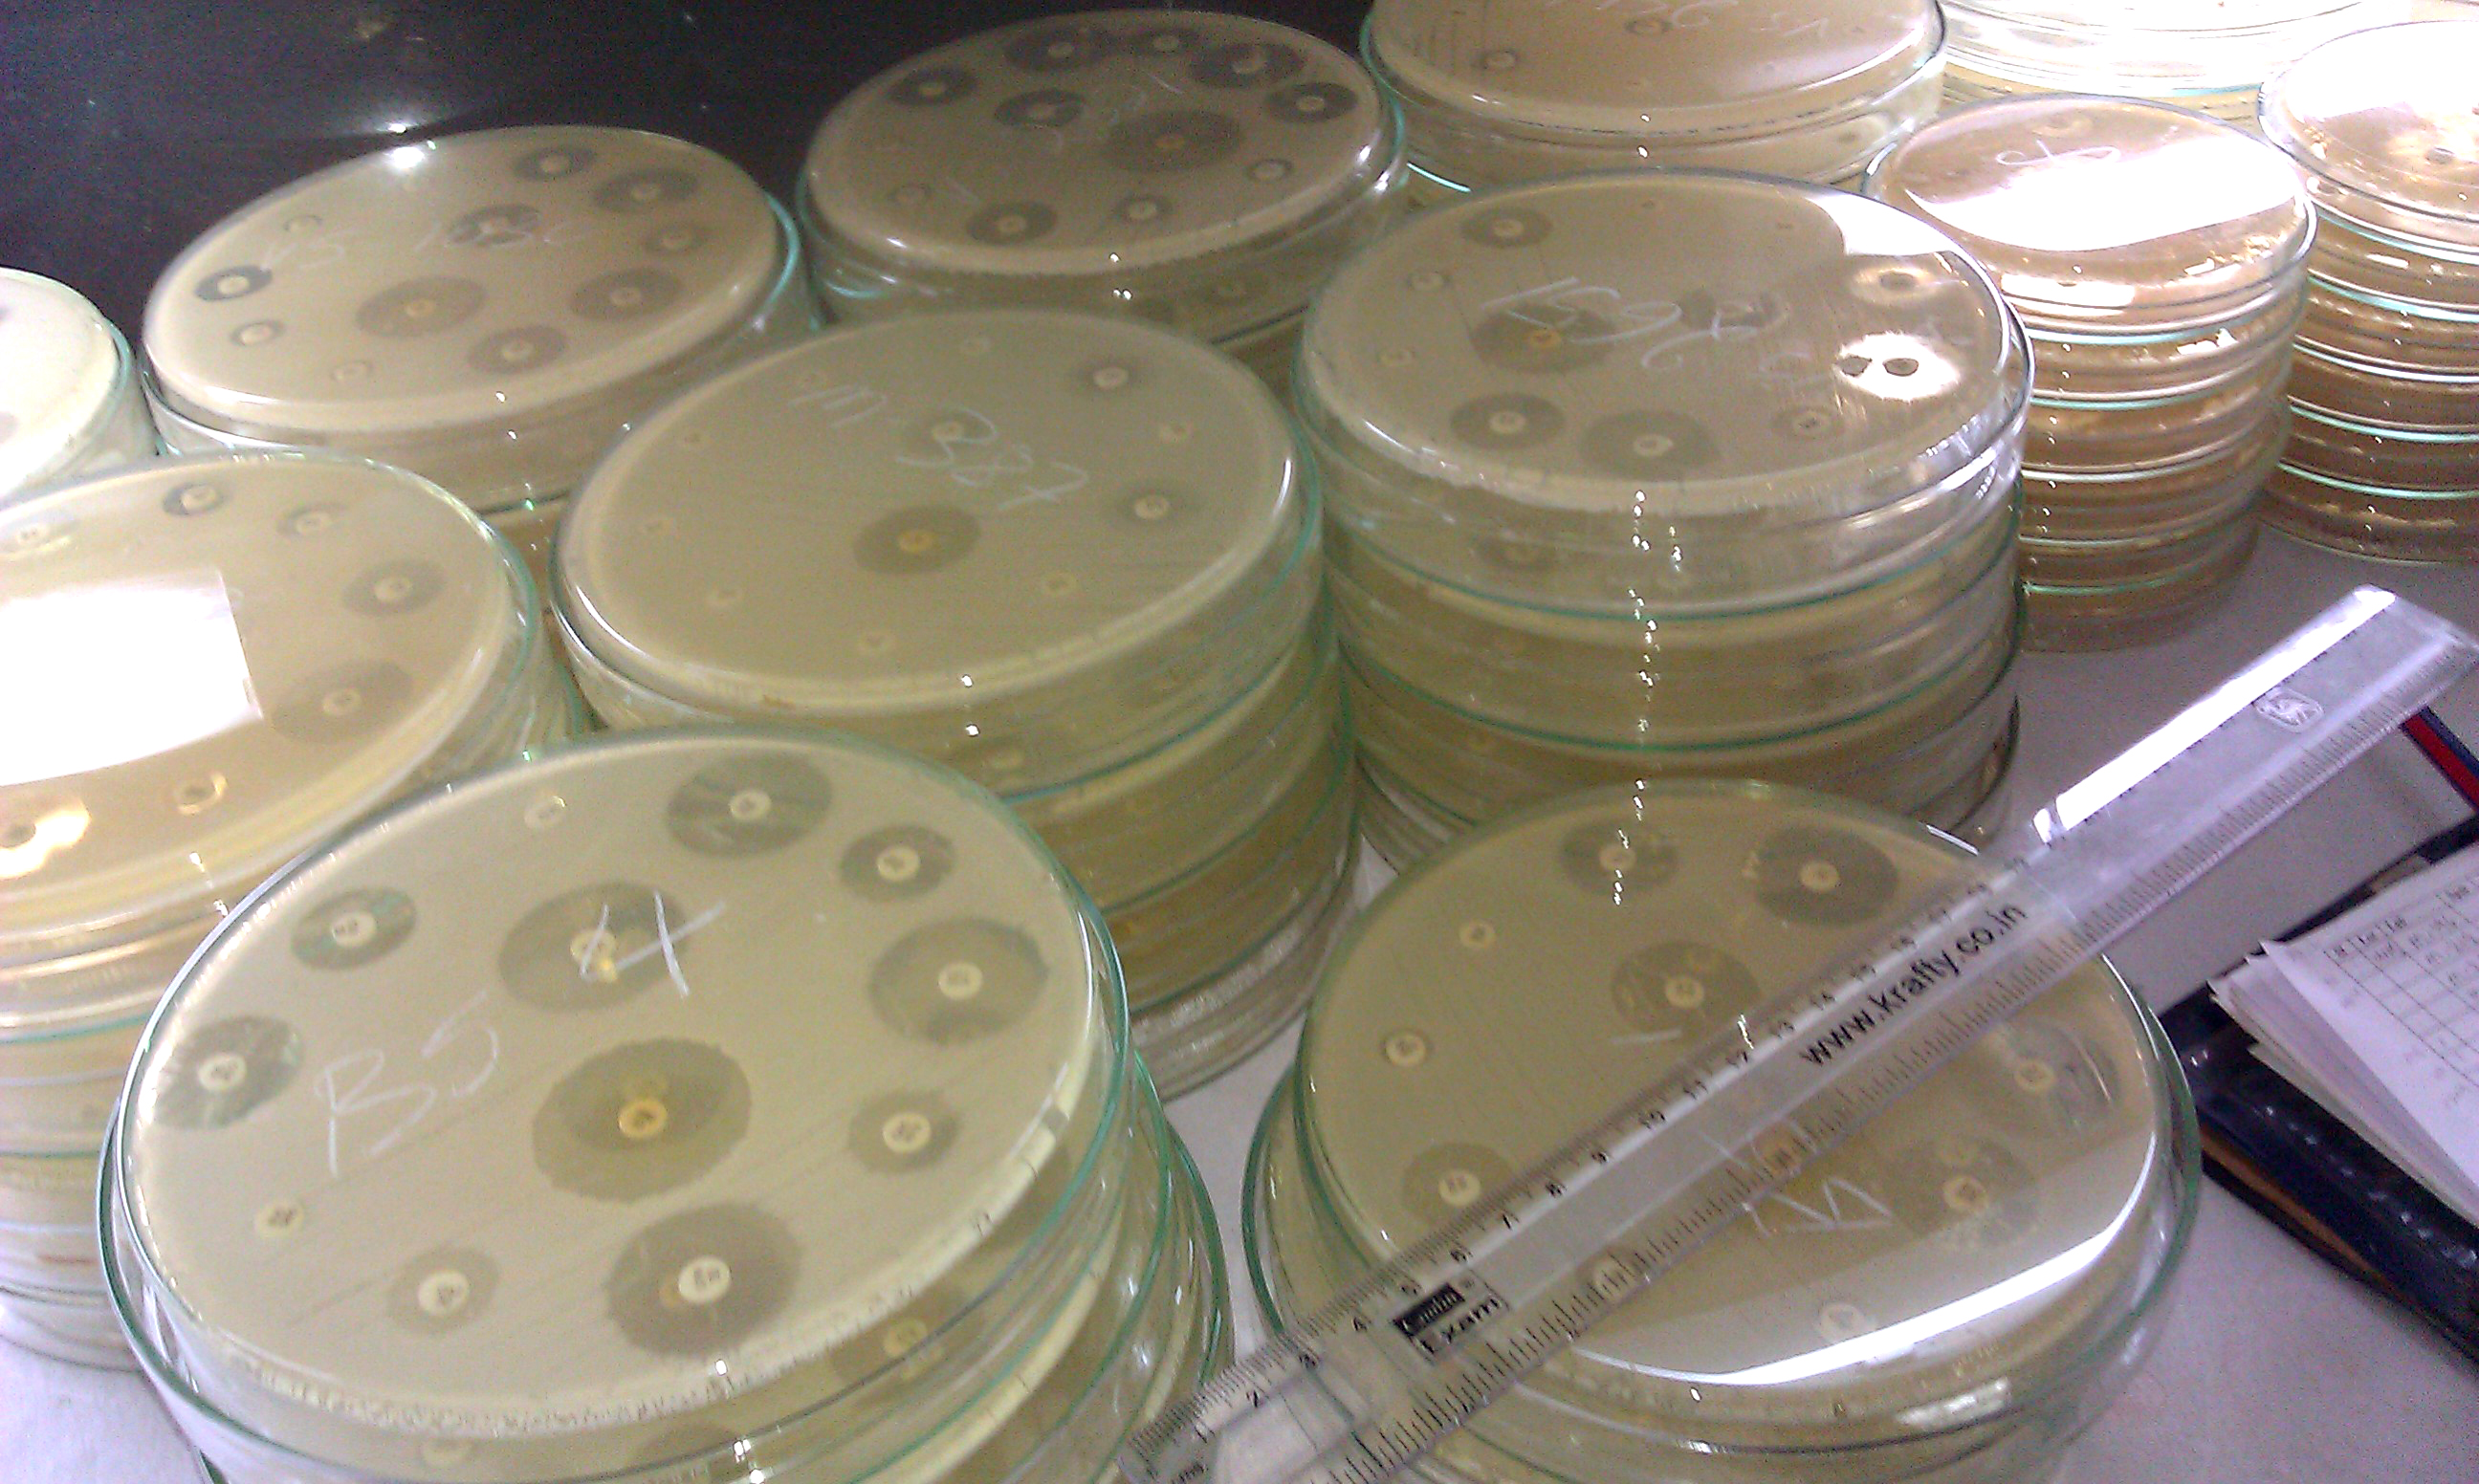
Sabia Covid-19. Fabricarea armelor biologice nu a fost niciodată mai ușoară

China. Glonțul partidului pe lângă urechile jurnaliștilor străini
Autoritățile chineze au declarat, marți, că jurnaliștii străini care lucrează în țară trebuie să se supună legile locale, după plecarea a doi reporteri australieni care se temeau că vor fi...